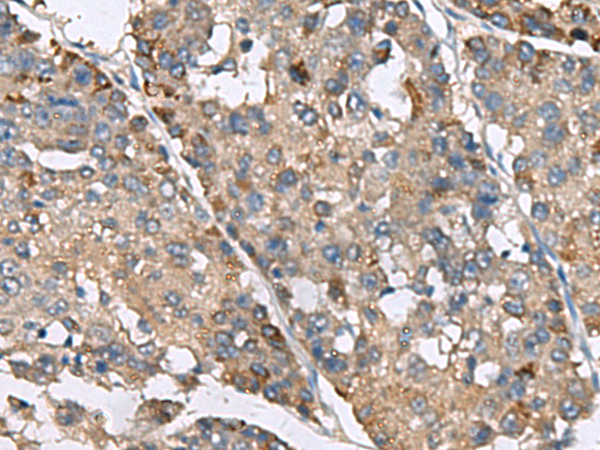
一抗

宿 主: Rabbit
技術(shù)規(guī)格
|
Background: |
This gene encodes a protein that belongs to the inositol phosphokinase (IPK) family. This protein is likely responsible for the conversion of inositol hexakisphosphate (InsP6) to diphosphoinositol pentakisphosphate (InsP7/PP-InsP5). It may also convert 1,3,4,5,6-pentakisphosphate (InsP5) to PP-InsP4 and affect the growth suppressive and apoptotic activities of interferon-beta in some ovarian cancers. Alternative splicing results in multiple transcript variants encoding different isoforms. |
|
Applications: |
ELISA, WB, IHC |
|
Name of antibody: |
IP6K2 |
|
Immunogen: |
Fusion protein of human IP6K2 |
|
Full name: |
inositol hexakisphosphate kinase 2 |
|
Synonyms: |
PIUS; IHPK2 |
|
SwissProt: |
Q9UHH9 |
|
ELISA Recommended dilution: |
5000-10000 |
|
IHC positive control: |
Human liver cancer |
|
IHC Recommend dilution: |
200-400 |
|
WB Predicted band size: |
49 kDa |
|
WB Positive control: |
K562 cell lysate |
|
WB Recommended dilution: |
500-2000 |




 購物車
購物車 幫助
幫助
 021-54845833/15800441009
021-54845833/15800441009